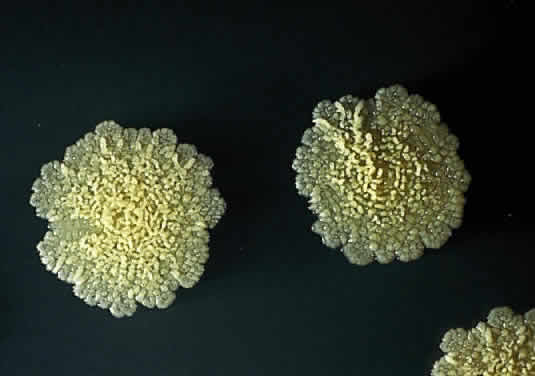

1. Lederer E: The mycobacterial cell wall. Pure Appl Chem 25:135, 1971 2. Hunter SW, Fujiwara T, Brennan PJ: Structure and antigenicity of the major specific glycolipid antigens of Mycobacterium leprae. J Biol Chem 257:15072, 1982 3. Kaplan G, Gandhi RR, Weinstein DE et al: Mycobacterium leprae antigen-induced suppression of T cell proliferation in vitro. J Immunol 138:3028, 1987 4. Vassalli P: The pathophysiology of tumor necrosis factor. Ann Rev Immunol 10:411, 1992 5. Kaufmann SHE: Immunity to intracellular bacteria. In Paul WE (ed): Fundamental
Immunology. 3d ed. New York, Raven Press, 1993 6. Paschal JF, Holland GN, Sison RF et al: Mycobacterium fortuitum keratitis: Clinicopathologic correlates and corticosteroid effects in
an animal model. Cornea 11:493, 1992 7. Gelber RH: Leprosy (Hansen's disease). In Mandell GL, Bennett JE, Dolin
R (eds): Principles and Practice of Infectious Diseases. New York, Churchill-Livingstone, 1995 8. Hussein N, Ostler HB: Hansen disease. In Pepose JS, Holland GN, Wilhelmus
KR (eds): Ocular Infection and Immunity. St. Louis, Mosby-Year Book, 1996 9. Smith DW: A guinea pig model of experimental airborne tuberculosis for evaluation
of the response to chemotherapy: The effect on bacilli in the initial
phase of treatment. Tubercle 72:223, 1991 10. Balasubramanian V, Wiegeshaus EH, Smith DW: Mycobacterial infection in guinea pigs. Immunobiology 191:395, 1994 11. North RJ, Izzo AA: Mycobacterial virulence.
Virulent strains of Mycobacterium tuberculosis have faster in vivo doubling times and are better equipped to resist growth-inhibiting functions
of macrophages in the presence and absence of specific immunity. J Exp Med 177:1723, 1993 12. Ueda K, Yamazaki S, Yamamoto S, Someya S: Spleen cell transfer induces T cell-dependent granulomas in tuberculous
nude mice. J Reticuloendothel Soc 31:469, 1982 13. Dunn PL, North RJ: Virulence ranking of some Mycobacterium tuberculosis and Mycobacterium bovis strains according to their ability to multiply in the lungs, induce lung
pathology, and cause mortality in mice. Infect Immun 63:3428, 1995 14. McCune RM, Feldmann FM, McDermott W: Microbial persistence. II. Characteristics of the sterile state of tubercle
bacilli. J Exp Med 123:469, 1996 15. Gangadharam PRJ, Perumal VK, Farhi DC, LaBreccque J: The beige mouse model for Mycobacterium avium complex (MAC) disease: Optimal conditions for the host and parasite. Tubercle 70:257, 1989 16. Lin R, Holland GN, Helm CJ et al: Comparative efficacy of topical ciprofloxacin for treating Mycobacterium fortuitum and Mycobacterium chelonae keratitis in an animal model. Am J Ophthalmol 117:657, 1994 17. Kircheimer WF, Storrs EE: Attempts to establish the armadillo (Dasyptus novemcinctus Linn.) as a model for study of leprosy. Int J Lepr 693, 1971 18. Dunn JP, Helm CJ, Davidson PT: Tuberculosis. In Pepose JS, Holland GN, Wilhelmus
KR (eds). Ocular Infection and Immunity. St. Louis, Mosby-Year
Book, 1996 19. Helm CJ, Holland GN: Ocular tuberculosis. Surv Ophthalmol 38:229, 1993 20. Dutt AK, Moers D, Stead WW: Short-course chemotherapy for extrapulmonary tuberculosis: Nine years' experience. Ann Intern Med 104:7, 1986 21. O'Brien TP, Matoba AY: Nontuberculous mycobacterial diseases. In Pepose
JS, Holland GN, Wilhelmus KR (eds): Ocular Infection and Immunity. St. Louis, Mosby-Year
Book, 1996 22. Bullington RH Jr, Lanier JD, Font RL: Nontuberculous mycobacterial keratitis: Report of two cases and review
of the literature. Arch Ophthalmol 110:519, 1992 23. Sugar J, Hill C: Leprosy. In Mannis MJ, Macsai MS, Huntley AC (eds): Eye
and Skin Disease. Philadelphia, Lippincott-Raven, 1996 24. Dana M-R, Hochman MA, Viana MAG et al: Ocular manifestations of leprosy in a noninstitutionalized community in
the United States. Arch Ophthalmol 112:626, 1994 25. Ross BC, Raios K, Jackson K, Dwyer B: Molecular cloning of a highly repeated DNA element from Mycobacterium tuberculosis and its use as an epidemiologic tool. J Clin Microbiol 30:942, 1992 26. Franzblau SG: Drug susceptibility testing of Mycobacterium leprae in the BACTEC 460 system. Antimicrob Agents Chemother 33:2115, 1989 27. Centers for Disease Control: Initial therapy for tuberculosis in the era
of multidrug resistance: Recommendations of the advisory council for
the elimination of tuberculosis. MMWR 42:1, 1993 28. Alwood K, Keruly J, Moore-Rice K et al: Effectiveness of supervised, intermittent therapy for tuberculosis in HIV-infected
patients. AIDS 8:1103, 1994 29. Woods AC, Wood R, Senterfit LB: Studies in experimental ocular tuberculosis. Arch Ophthalmol 59:559, 1958 30. Nanda M, Pflugfelder SC, Holland S: Mycobacterium tuberculosis scleritis. Am J Ophthalmol 108:736, 1989 31. Swenson JM, Wallace RJ Jr, Silcox VA, Thornsberry C: Antimicrobial sensitivity of five subgroups of Mycobacterium fortuitum and Mycobacterium chelonae. Antimicrob Agents Chemother 28:807, 1985 32. Esperitu CG, Gelber R, Ostler HB: Chronic anterior uveitis in leprosy: An insidious cause of blindness. Br J Ophthalmol 75:273, 1991 |